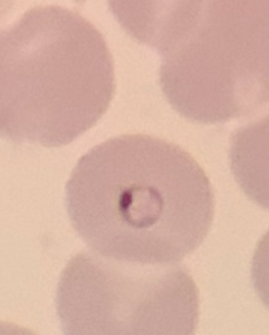
<p>100x</p>
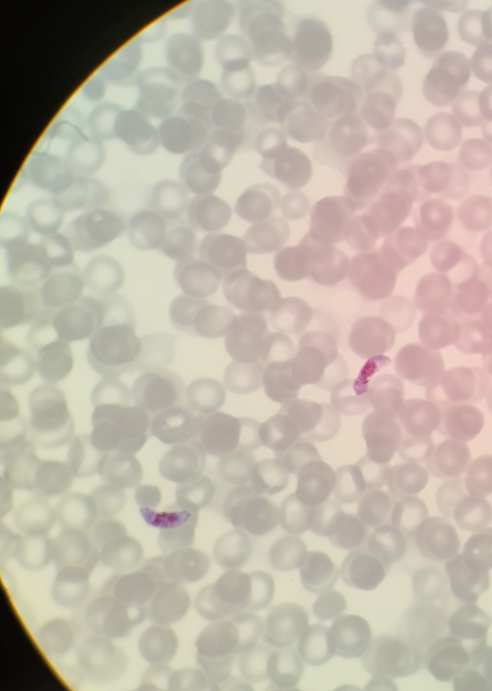
<p>100x</p>
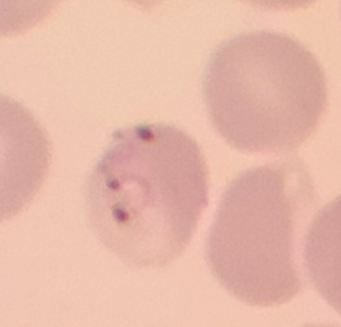
<p>100x</p>
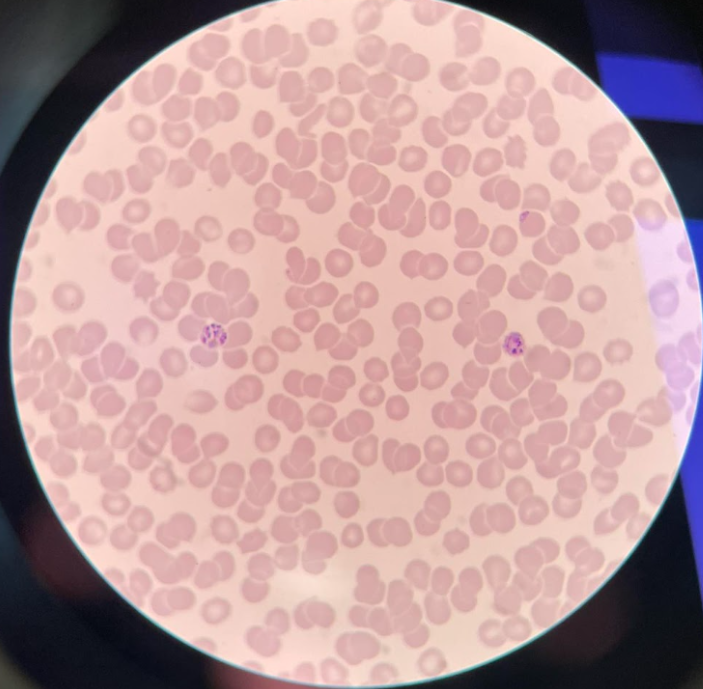
<p>100x</p>

1/48
Looks like no tags are added yet.
Name | Mastery | Learn | Test | Matching | Spaced | Call with Kai |
|---|
No analytics yet
Send a link to your students to track their progress

100x
Acanthamoeba castellanii - trofozoit

40x
Ascaris lumbricoides hominis - jajo

Ascaris lumbricoides hominis - samiec i samica

40x
Balantidium coli - trofozoit

100x
Cryptosporidium spp. - oocysta ze sporozoitami

40x
Clonorchis sinensis - jajo

lupa
Clonorchis sinensis - marita

lupa
Dipylidium caninum - człon maciczny

40x
Dicrocoelium dendriticum - jajo

40x
Dicrocoelium dendriticum - jajo

lupa
Dicrocoelium dendriticum - marita

lupa
Diphyllobothrium latum - człon rozrodczy

40x
Diphyllobothrium latum - jajo

40x
Diphyllobothrium latum - jajo

100x
Entamoeba histolytica - cysta

100x
Entamoeba histolytica - cysta

100x
Entamoeba histolytica - trofozoit

40x
Enterobius vermicularis - jajo

40x
Enterobius vermicularis - jajo

5x
Enterobius vermicularis - samica

40x
Fasciola hepatica - jajo

lupa
Fasciola hepatica - marita

5x
Hymenolepis nana - człon maciczny

5x
kleszcz

100x
Leishmania donovani - amastigota

100x
Giardia intestinalis - cysta

100x
Giardia intestinalis - cysta

100x
Giardia intestinalis - trofozoit

Loa loa - mikrofilaria

100x
Leishmania tropica - promastigota
100x
Plasmodium spp. - pierścień

5x
pchła
100x
Plasmodium falciparum - gametocyt
100x
Plasmodium falciparum - pierścień
100x
Plasmodium vivax - schizont

40x
Schistosoma haematobium - jajo

40
Schistosoma japonicum - jajo

40x
Schistosoma mansoni - jajo

40x
Taenia spp. - jajo

100x
Trypanosoma brucei gambiense - trypomastigota

100x
Toxoplasma gondii - trofozoit

5x
Taenia saginata - człon maciczny

5x
Trichinella spiralis - larwa

5x
Trichinella spiralis - larwa

40x
Trichuris trichiura - jajo

lupa
Trichuris trichiura - samiec i samica

lupa
Trichuris trichiura - samiec

100x
Trichomonas vaginalis - trofozoit

5x
wesz